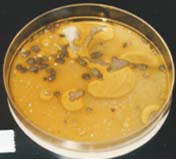

|
| |
|
| |
| 1. Shale Problems and Dynamic Stress: |
| |
 |
Shale has capability of composition changing with time, cataionic exchange in Shale formation results in osmotic ion exchange and thus, Shale formation collapses. |
 |
Is your Shale formation sloughing brittle, gumbo plastic, or hydrate - swelling! |
 |
Learn more on this and find out the best solution to your Shale problems |
 |
Learn how to conduct research and experiments to analyze your Shale formation |
| |
|
| |
 |
|
 |
| |
|
| |
|
| |
|
|
|
| |
| 2. Formation Damage: |
| |
 |
Formation damage is caused by extra pressure applied on the drilled formation, chemical un-compatibility, fines plugging, or grain re-positioning. |
 |
How can you control formation damage? |
 |
Is it possible to drill the pay zone without causing any damage to the face? |
 |
Learn how to conduct research and experiments to analyze your Shale formation |
| |
|
| |
 |
 |
| |
|
| |
 |
 |
| |
|
|
|
| |
| 3. Surface Mud Logging |
| |
 |
What is gas ratio, the quick look analysis? |
 |
Ratio plot and interpretation guide lines |
| |
|
| |
 |
 |
| |
|
|
|
| |
| 4. Open Hole Logging Tools and Interpretations: |
| |
 |
Full set open hole tools (Resistivity, Neutron, Density, GR, Micro, Acoustic) |
 |
Well Testing tools and analysis |
 |
Well Image tools |
 |
Production tools in horizontal wells |
 |
Resistivity in this bed |
 |
Low resistivity pay reservoirs |
 |
Archie equation and its validity |
| |
|
| |
 |
 |
| |
|
| |
 |
 |
| |
|
| |
 |
| |
|
|
|
| |
| 5. Cased Hole Logging Tools and Interpretations: |
| |
 |
Monitoring tools |
 |
 |
Production tools in vertical and horizontal wells |
 |
Noise log tools and their analysis |
 |
Cement logging tools, quantification of data and full analysis |
 |
Corrosion logging tools and full analysis |
 |
Chemical cutters |
 |
Perforations, principle, facts and truths, simulation and full analysis |
| |
|
| |
|
|
| |
|
|
|
| |
| 6.
Cement Components and Cement Log Analysis: |
| |
 |
How cement is manufactured, how it is mixed, what is critical cement setting time |
 |
What are the differences between cement classes? |
 |
How cement sets |
 |
Cement – mud interaction problems |
 |
Cementing and its complications |
 |
Cement logging tools and full interpretation |
| |
|
| |
 |
 |
| |
|
| |
 |
 |
 |
| |
|
| |
|
| |
|
|
|
| |
| 7. Corrosion of Metals, Corrosion Logging Tools & Interpretation: |
| |
 |
How does corrosion happen? What affects corrosion of pipes and equipment? |
 |
What are corrosion agents? |
 |
Forms of corrosion and their mechanism |
 |
New technology corrosion logging tools and interpretations |
| |
|
| |
 |
 |
| |
|
|
|
|
  |
Estimated time Oil left for Human Race on Earth
time counter
|
|